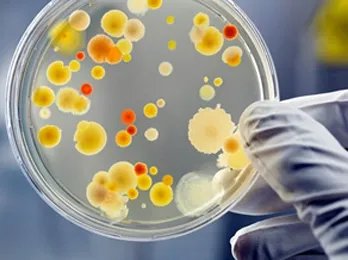

Nuestro periodista Gustavo Llabra, entrevistó esta mañana al Doctor Acosta, experto en investigaciones microbiológicas. En "Media Mañana" por Am 730, Fm 103.5 "La Radio de Todos" .
Nuestro periodista Gustavo Llabra, entrevistó esta mañana al Doctor Acosta, experto en investigaciones microbiológicas. En "Media Mañana" por Am 730, Fm 103.5 "La Radio de Todos" .